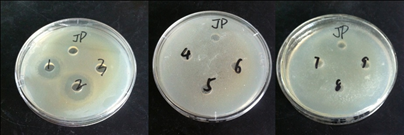

Ai-dong Sun
Email: adsun@bjfu.edu.cn
© 2019 Sift Desk Journals. All Rights Reserved
VOLUME: 4 ISSUE: 3
Page No: 670-679
Ai-dong Sun
Email: adsun@bjfu.edu.cn
Nan Cui, Yue Zhu, Ning Zhu, Fen-mei Li, Jia-qi Sun, Ai-dong Sun*
Department of Food Science and Engineering, College of Biological Sciences and Technology, Beijing Forestry University, Beijing 100083, China
Beijing Key Laboratory of Forest Food Processing and Safety, Beijing Forestry University, Beijing, 100083, China
Lars-Henrik Heckmann(lhlh@dti.dk)
Kui Lu(luckyluke@haue.edu.cn)
Ai-dong Sun, Nan-Cui,Yue Zhu, Ning Zhu, Fen-mei Li, Jia-qi Sun, Preparation of ACE inhibitory peptides from Tenebrio molitor and antibacterial activity (2019) SDRP Journal of Food Science & Technology 4(3)
This research aimed to obtain active peptides that exert remarkable inhibitory effects on Angiotensin-converting enzyme (ACE). The ACE inhibitory peptides from T. molitor were were prepared by hydrolyzing Tenebrio molitor powders with papain, separated by using ultrafiltration membranes. Five molecular weight fractions were obtained. Sephadex G-15 was used to separate the fraction with molecular weight < 3 kDa through the different concentrations of the enzyme solutions. Results showed that 100 mg/mL was the optimal concentration, and the elution peaks were divided into three groupsM1,M2,M3. The M2 component showed the highest activity,which was analyzed and found to be abundant and diverse. The molecular weight of M2, which was composed of three amino acid residues. The inhibitory activities of the enzymatic hydrolysis solution, the ultrafiltration component, and the chromatography component against indicator bacteria were measured. The enzymatic hydrolysis solution and the component >30 kDa in molecular weight exhibited inhibitory effects on the three indicator bacteria.
Keywords: Tenebrio molitor, ACE inhibitory peptide, isolation, purification, antibacterial activity
Angiotensin-converting enzyme (ACE) is a two-peptide carboxyl group that regulates human blood pressure. In the renin–angiotensin system and the kallikrein–kinin system, ACE can induce a strong contraction of the vascular smooth muscle and thus an increase in blood pressure (Shi, Jin & Yuan, 2004). Meanwhile, ACE inhibits bradykinin, the kinin with a diastolic blood vessel function in the endogenous blood pressure system of the human body (Cushmanh & Cheung, 1971). Therefore, inhibition of ACE activity plays an important role in blood pressure regulation. Currently, antihypertensive peptides can be prepared through three types of extraction methods, namely, direct extraction, fermentation, and enzymatic hydrolysis. Each extraction method has its inherent advantages and disadvantages.
Antihypertensive peptides derived from food proteins by enzymatic hydrolysis have gained wide attention because of their high safety (Liu & Wu Qiong, 2007). Several studies have reported the preparation of ACE inhibitory peptides from different food protein hydrolysates. Therefore, isolation of ACE inhibitory peptides from foodborne materials is a new developmental trend. At present, ACE inhibitory peptides have been isolated from various foodborne proteins, and these peptides can be divided into two categories(Zhang C&Sun L.C.,2018). One stems from natural plants(Wang.C.&Tu.M.L,2018)., such as peanuts(Shi, A.M& Liu, H.Z,2014), soybean, rapeseed(Ren.H,2011), and corn(Manoharan.S.&Shuib.A.S); the other originates from animals, such as egg white, chrysalis(Deng Z.Z.&Liu Y.J.,2018), and small yellow croaker(Wang X.&Yu H.,2017). All ACE inhibitory peptides that have been reported thus far contain 2–15 peptides, most of which contain hydrophobic and aromatic amino acids with molecular weights ranging from 200 Da to 1500 Da(García-Moreno P.J.&Espejo-Carpio F.J.,2015). Recent studies have focused on the antibacterial activity of peptides because of their potential to be developed as a new type of antibiotics or food preservatives that have the advantages of high safety, nontoxic side effects, simple materials, and green preparation process(Soriano-Santos J, Escalona-Buendía HB,2015).
Tenebrio molitor, also known as large mealworm or bread worm, belongs to the Class Insecta (Coleoptera: quasi Carabidae) ( Zhang LS.& Zhang JX.,2009 ). This insect contains high contents of proteins and amino acids. T. molitor has been used to produce health oral liquids containing antioxidant peptides and amino acids. Studies on the ACE inhibitory peptides of T. molitor proteins mostly focused on the optimization of enzyme screening and extraction; few reports about the separation and purification of these peptides are available. In the present experiment, T. molitor proteins as a source of animal proteins were hydrolyzed with papain to prepare ACE inhibitory peptides. The peptides were isolated and purified via ultrafiltration and Sephadex gel chromatography. The amino acid composition, molecular weight distribution, and ACE inhibitory activity of the ACE inhibitory peptides were then investigated. This study aims to provide a basis for the research and development of ACE inhibitory peptides. The antibacterial activities of the obtained ACE inhibitory peptides were also assessed( Wang.Z.L. & Wang X.M.,2018). This study has a positive significance for the storage, preservation, biological control, and breeding of ACE peptides. It also has broad application prospects in the fields of medicine, health, agriculture, food industry, etc.
2.1 Materials
|
Materials |
Company |
|
Defatted powder of Tenebrio molitor protein (protein content 63.17%) |
Chongqing Fujiang Biological Technology Co. Ltd.
|
|
Papain PTN6.0S(1.89×104 U/g) |
Sigma company in American |
|
ACE |
Sigma company in American |
|
N-[3-(2-furylacryloyl)]-L- phenyalanyl-glycyl-glycine |
Sigma company in American |
|
Sephadex gel chromatography |
Sigma company in American
|
2.2 Equipment’s
|
Equipment’s |
Company |
|
Vivaflow tangential flow ultrafiltration |
Germany Sartorius Group Co. ltd.; |
|
HHS4 thermostatic bath |
Shanghai Pudong Yuexin science instrument factory |
|
LB941 enzyme standard instrument |
Germany Berthold company |
|
Bench top refrigerated centrifuge ;FD-1 freeze dryer |
Thermo Fisher Scientific company in America |
|
PH PHS-25 instrument |
Shanghai Precision Scientific Instrument Co., Ltd. |
|
FA10004A electronic balance |
Shanghai precision instrument factory |
|
glass column (1.6 * 60cm) |
Shanghai Jinhua chromatography equipment factory |
|
BSZ–100 Automatic partial collector DHL-A Computer constant current pump |
Qingpu Shanghai West Instrument Factory |
|
UV spectrophotometer |
Beijing Purkinje General Instrument Co. company |
|
L-8900 amino acid analyzer |
Hitachi, japan |
|
4800 Plus MALDI TOF/TOF™ Mass spectrometer |
AB SCIEX company in America |
|
SPX-80BSH- II biochemical incubator |
Shanghai CIMO Instrument Manufacturing Co. ltd. |
|
HPS-250 Biochemical culture box |
Dongming Harbin medical instrument factory |
|
TomySX-500 high pressure sterilization pot |
Shanghai Mai Medical Technology Co., ltd |
|
HFsafe-1500 manual type bio safety cabinet |
Hongkong force Kang Development Co., ltd |
2.3 Methods
2.3.1 Preparation of ACE inhibitory peptides from T. molitor
A certain amount of T. molitor protein was configured to a 7 g/100 mL substrate concentration of protein solution, and the pH was adjusted to 6.5. Then, 1% papain was added and then placed under a constant temperature bath of 55 °C to induce enzymatic hydrolysis for 7 h. The enzyme solution was placed in a boiling water bath for 10 min to inactivate enzymes and then centrifuged at 10 000 r/min for 10 min at 4 °C. The supernatant was lyophilized to prepare highly active T. molitor ACE inhibitory peptides for the determination of ACE inhibition rate.
2.3.2 Determination of ACE inhibition rate
Shalaby’s method was employed with modifications (Shalaby, Zakora & Otte, 2006). FAPGG was used as the substrate, and a microplate reader was used to determine ACE inhibition rate.
ACE solution was prepared as follows. Distilled water (1 mL) was slowly injected into 0.1 U of ACE glass bottle, mixed, and then set aside. In specific, 10 µL of aqueous ACE and 10 µL of ACE inhibitory peptide sample solution (1 mg/mL) were added to the enzyme label plate, followed by 150 µL of substrate solution (1.0 mmol/L FAPGG dissolved in 50 mmol/L Tris HCl containing 0.3 mol/L NaCl, pH 7.5). The solution was then preheated at 37 °C for 5 min to initiate the reaction. The microhole plate was placed in the enzyme standard instrument, and the absorbance of A1 at 340 nm was recorded. The absorbance at 340 nm was determined again after 30 min. The blank group comprised 10 µL of the substrate instead of the ACE inhibitory peptides of the sample solution. The initial and final absorbance values of the blank group were recorded as A01 and A02, respectively.
The change (△A Inhibitors= A1-A2, △Blank= A01-A02) in the absorbance value was used to calculate the inhibition rate of ACE.
2.3.3 Ultrafiltration separation of ACE inhibitory peptides
Membranes with different molecular weights were loaded in the ultrafiltration system.
Before adding the sample, the membranes were washed with pure water at room temperature for ultrafiltration. Enzymatic hydrolysates were separated though 5, 10, 3, and 30 kDa ultrafiltration membranes by using the Vivaflow ultrafiltration system. After ultrafiltration, enzymolysis fluid was divided into five parts: group I (M > 30 kDa), group II (10 kDa < m < 30 kDa), group III (5 kDa < m < 10 kDa), group IV (3 kDa < m < 5 kDa), and group V (m < 3 kDa). After vacuum freeze drying, the ACE inhibition rate of each component was determined.
2.3.4 Gel chromatography separation of ACE inhibitory peptides
Sephadex G-15 was treated and then placed into a 1.6 cm × 60 cm glass column. The T. molitor ACE inhibitory peptides were dissolved in distilled water, and solutions with different concentrations of 100, 200, and 300 mg/mL were prepared. A 3 mL sample was added and then flowed with distilled water to 0.3 mL/min. One tube was collected every 10 min, and a total of 50 tubes were collected. Absorbance was measured at 280 nm by using a UV spectrophotometer. The optimal elution peaks were collected and frozen dry. The inhibition rate of ACE was determined.
2.3.5 Molecular weight distribution of T. molitor ACE inhibitory peptides
To determine the molecular weights of the ACE inhibitory peptides, the highly active M2 component purified by Sephadex G-15 was identified through matrix-assisted laser desorption/ionization time-of-flight mass spectrometry (MALDI-TOF-MS). First, the trypsin enzyme of horse heart myoglobin was used as the standard peptide for the external standard calibration of the instruments (error ≤ 0.1u, relative standard deviation ≤ 10 ppm). MS parameter settings were as follows: a mass of data acquisition using the MS-positive-2KV reflection mode, MALDI source as the laser source, scanning range m/z of 120–760, laser energy of 5000, and positive ion mode. The instrument control software used was 4800 Explorer TM, and the mass-to-charge ratio (m/z) was a single-isotope mass number. The spotting method was as follows. A sample was dissolved in ultrapure water to a concentration of 5 μg/μL, 0.5 μL points were taken on the stainless steel MALDI target plate after natural drying, and 0.5 μg/μL α-cyano-4-hydroxy cinnamic acid served as a matrix. After natural drying, test samples were submitted for MS detection( Ibrahim HR&Ahmed AS,2017).
2.3.6 Amino acid analysis of T. molitor ACE inhibitory peptides
The amino acid contents of the samples were analyzed through the following four steps: tryptophan hydrolysis, peroxyformic acid removal, drying, and determination. To oxidize the samples completely, 0.100 g of T. molitor ACE inhibitory peptides were placed in a hydrolysis tube, added with 4.2 mol/L of sodium hydroxide hydrolysis tryptophan samples and 1.0 mL of formic acid solution, and then incubated at 25 °C for 3 h. The oxidation reaction was terminated by adding 1 mL of ethanol. The dried flask into which the remaining liquid sample from the hydrolysis tube was poured was connected and placed in the vacuum unit to dry the samples. After drying under reduced pressure termination, the flask was rinsed with ultrapure water and then dried. A second drying step was conducted, and the above process was repeated thrice to volatilize the residual peroxyformic acid sufficiently. HCl (10 mL, 6 mol/L) was added to the rest of the sample solution, three drops of phenol were added with a glue head dropper, and the vials were frozen in liquid nitrogen for 3–5 min. Then, the vials were connected with pump. After drying the vials, they were pumped with nitrogen, and the operation was repeated thrice. In this state, the vials were sealed and placed in the oven at 110 °C for 22 h. Samples that were sufficiently hydrolyzed were removed from the loft drier and cooled to room temperature. The sample tubes were opened, the hydrolyzing liquid was filtered into a 50 mL volumetric flask, and flushing fluid was obtained by washing the vials repeatedly with ultrapure water. A 1.0 mL aliquot of the sample was transferred from the 50 mL volumetric flask into a 5 mL volumetric flask and then placed in a vacuum dryer.
The residue was dissolved with ultrapure water and then dried; this process was repeated twice. Finally, the residue after evaporation was dissolved with 1 mL of disodium hydrogen phosphate–citrate buffer (pH 2.2) before being assayed by a machine. A 0.2 mL aliquot of the mixed standard amino acid liquid was extracted and placed in the 5 mL volumetric flask containing phosphate dibasic–citrate buffer (pH 2.2) to a constant volume. The diluent concentration of 1.0 nmol/10μL was used as the standard amino acid. Subsequently, ACE inhibitory peptides were injected into the amino acid analyzer to measure the amino acid content of the samples.
2.3.7 Antimicrobial testing of T. molitor ACE inhibitory peptides
A 300 mg sample of the ACE inhibitory peptides dissolved in 1 mL of sterile ultrapure water was taken in a clean bench. After 30 min of irradiation with ultraviolet rays, the sample was filtered twice through a 0.22 μm microfiltration membrane. Water agar culture medium (10 mL, 50 °C) was added in the sterilization culture dish. After cooling, four Oxford cups were placed equidistantly in a Petri dish. The LB solid medium (20 mL) was removed from the oven, cooled to approximately 50 °C, and then added with 1 mL of the test bacteria (1 × 106 CFU/mL). The mixture was slowly poured into the center of the dish, and the Oxford cups were pulled out after the mixture cooled and solidified. One hole was served as the negative control, which contained 200 μL of sterile ultrapure water. Each of the three other holes was added with 200 μL of the T. molitor ACE inhibitory peptides that were obtained through different separation–purification methods. The culture dish was developed through incubation at 37 °C incubator for 24 h.
The inhibition zone diameter was measured with a Vernier caliper behind the culture dish under irradiation reflected light, and the average was calculated after three times of vertical measurement.
3.1 Ultrafiltration of T. molitor ACE inhibitory peptides
As shown in Fig. 1, the inhibition rates of the ACE inhibitory peptides with different molecular weights differed after ultrafiltration. The ACE inhibitory effect of the component > 3 kDa in molecular weight was weaker than that of the enzymatic liquid. Only the component < 3 kDa in molecular weight (component V) showed a higher inhibition rate than the enzymatic liquid. Such results indicate that the most effective ingredients of T. molitor ACE inhibitory peptides originated from the component V. The results also confirmed that the ACE inhibitory peptides mainly constitute small peptides. Hence, the component V was adopted for all subsequent purification experiments.

Fig. 1 The ACE inhibitory activity of isolated fractions from Tenebrio molitor protein power after ultrafiltration
3.2 Sephadex G15-isolated ultrafiltration fraction of T. molitor ACE inhibitory peptides
As shown in Figures 2, 3, and 4, the V constituent was obtained after ultrafiltration of T. molitor ACE inhibitory peptides. Different concentrations of the sample were selected, and three chromates appeared through Sephadex G15. The effect of the peak at the 200 mg/mL concentration was not satisfactory, whereas that of the peak at 300 mg/mL was not enough to separate the gel filtration profiles. The sample concentration of 100 mg/mL was selected on the basis of the effect of the elution peak(M1, M2, and M3). The liquid of the elution peak was repeatedly isolated and collected, concentrated, and then freeze-dried. Then, ACE inhibition rate was determined. Figure 5 shows the separation by Sephadex G15. The M2 constituent showed the highest ACE inhibition rate (i.e., approximately 72.11%), with an IC50 of 0.6052 mg/mL. The isolated liquid was subjected to chromatography, concentrated, and then freeze-dried. Finally, the remaining liquid was used for further analyses.

Fig. 2 Glucan gel chromatography spectrum diagram at the concentration of 100 mg/mL

Fig. 3 Glucan gel chromatography spectrum diagram at the concentration of 200 mg/mL

Fig.4 Glucan gel chromatography spectrum diagram at the concentration of 300 mg/mL

Fig.5 The ACE inhibitory activity of isolated fractions from Tenebrio molitor protein power after Sephadex G–15 gel purify at the concentration of 100 mg/mL
3.3 Amino acid composition of T. molitor ACE inhibitory peptides
Table 1 shows the rich amino acid contents of the T. molitor ACE inhibitory peptides; in particular, the peptides contained 18 amino acids and seven essential amino acids. The amino acid with the highest content in the larvae of T. molitor was Pro (29.04%), followed by Glu (18.06%) and Val (6.78%). The three amino acids accounted for approximately 55% of the total amino acids. The discovery of protein food derived from antihypertensive peptides has proven that peptides whose N-terminal contains Ala, Val, Leu, and Gly residues and whose C-terminal contains Arg, Tyr, Phe, and Pro residues can lower blood pressure. The T. molitor ACE inhibitor peptides containing a high content of the above amino acids can be inferred to possess a relatively satisfactory ACE inhibition effect.
Table 1: Amino acid composition of M2 part (%) (g/100g protein)
|
Amino |
Content |
Amino |
Content |
|
Asp |
1.10 |
Leu |
5.26 |
|
Thr |
1.74 |
Tyr |
6.21 |
|
Ser |
1.59 |
Phe |
3.86 |
|
Glu |
18.06 |
Lys |
0.45 |
|
Gly |
5.49 |
His |
3.18 |
|
Ala |
6.40 |
Arg |
2.88 |
|
Val |
6.78 |
Pro |
29.04 |
|
Met |
1.63 |
Trp |
0.08 |
|
Ile |
3.75 |
Cys |
2.50 |
3.4 Molecular weight distribution of T. molitor ACE inhibitory peptides
Strong signal peaks were observed in the mass spectrogram. Among the three signal peaks, the 379.1 signal peak was the molecular ion peak (M + H)+, which indicated that the molecular weight of the peptide segment was 378 Da. The ACE inhibitory peptides may be synthesized by the dehydration condensation of three amino acids (i.e., tripeptide). The molecular weight of the tripetide comprising Gly, Arg, and Phe was 378 Da, and the individual molecular weights of these three amino acids were 75, 174, and 165 Da, respectively. The tripeptide had six compound modes through the dehydration condensation of amino acids: Gly–Arg–Phe, Gly–Phe–Arg, Arg–Gly–Phe, Arg–Phe–Gly, Phe–Arg–Gly, and Phe–Gly–Arg. Basing from the sequence of the peptide segments, we concluded that Phe was a C-terminal amino acid through the characteristic ion 166.0033 in the mass spectrogram; that is, Phe provided a H+ in a −NH2 during the formation of the tripeptide. Meanwhile, Arg was the intermediate amino acid of the peptide through the characteristic ion 156.0923 in the mass spectrogram; that is, Arg provided a H+ in a −NH2 and a OH- in a –COOH during the formation of the tripeptide. Therefore, Gly may provide OH- and then produce the characteristic ion 58. However, data collection was started after 120. Thus, the characteristic ion 58 was not observed in the mass spectrum. Basing from the characteristic ion 232.0958, we inferred that the ions formed after -Gly-Arg-Phe lost -Phe residue. Therefore, the amino acid sequence of the tripeptide may be Gly-Arg-Phe.

Fig.6 Mass spectra (c) of M2
3.5 Inhibitory activity of T. molitor ACE inhibitory peptides toward Alternaria fungus
As shown in Table 2 and Figure 7, the ACE inhibitory peptides that underwent enzymolysis and purification showed fungal inhibitory activities. The ACE inhibitory peptides > 10 kDa and < 30 kDa in molecular weight displayed the strongest inhibitory effect, with an inhibition zone of approximately 5.15 mm. The M1 component exhibited a stronger antibacterial effect compared with the hydrolysates < 3 kDa in molecular weight. This result may be attributed to the fact that peptides of low molecular weight have less polypeptide fragments with inhibitory effects on Alternaria fungus. A. enzymatic hydrolysis solution B. molecular weight greater than 30 kDal C. molecular weight between10 kDal and 30 kDal D molecular weight between 5 kDal and 10 kDal E. molecular weight between 3 kDal and 5 kDal F. molecular weight less than 3 kDal G. chromatography M1 H. chromatography M2 I. chromatography M3.

Fig. 7 The antibacterial effect against Alternaria alternata of ACE inhibitory peptide from tenebrio molitor
1. enzymatic hydrolysissolution B. molecular weight greater than 30 kDal C. molecular weight between10 kDal and 30 kDal D molecular weight between 5 kDal and 10 kDal E. molecular weight between 3 kDal and 5 kDal F. molecular weight less than 3 kDal G. chromatography M1 H. chromatography M2 I. chromatography M3
Table 2 :The antibacterial against Alternaria alternata of Tenebrio Molitor ACE inhibitory peptide
|
Types |
Diameter of antibacterial circle(mm) |
|
enzymatic hydrolysis solution |
4.55±0.50 |
|
M>30 kDal |
2.76±0.50 |
|
10 kDal<M<30 kDal |
5.15±0.14 |
|
5 kDal<M<10 kDal |
4.29±0.28 |
|
3 kDal<M<5 kDal |
1.87±0.42 |
|
<3 kDal |
2.77±0.09 |
|
M1 |
4.49±0.28 |
|
M2 |
none |
|
M3 |
none |
3.6 Inhibitory activity of T. molitor ACE inhibitory peptides on Escherichia coli
As shown in Table 3 and Figure 8, the ACE inhibitory peptides that underwent enzymolysis and purification demonstrated a certain inhibitory effect on E. coli. The ACE inhibitory peptides > 30 kDa in molecular weight exhibited the strongest inhibitory effect, with an inhibition zone of approximately 7.37 mm. The M1 component showed a stronger antibacterial effect compared with the hydrolysates < 3 kDa in molecular weight. The inhibitory effect was satisfactory, with an inhibition zone of 7.22 mm. This result may be attributed to the fact that the peptides have polypeptide fragments with inhibitory effects on E. Coli.
Table 3:The antibacterial against Escherichia coli of Tenebrio Molitor ACE inhibitory peptide
|
Numbers |
Types |
Diameter of antibacterial circle(mm) |
||
|
1 |
enzymatic hydrolysis solution |
6.22±0.18 |
|
|
|
2 |
M>30 kDal |
7.37±0.49 |
|
|
|
3 |
10 kDal<M<30 kDal |
none |
|
|
|
4 |
5 kDal<M<10 kDal |
none |
|
|
|
5 |
3 kDal<M<5 kDal |
none |
|
|
|
6 |
<3 kDal |
3.23±0.39 |
|
|
|
7 |
M1 |
7.22±0.25 |
|
|
|
8 |
M2 |
none |
|
|
|
9 |
M3 |
none |
|
|

Fig. 8 The antibacterial effect against Escherichia coli of ACE inhibitory peptide from tenebrio molitor
1. enzymatic hydrolysissolution 2. molecular weight greater than 30 kDal 3. molecular weight between10 kDal and 30 kDal 4. molecular weight between 5 kDal and 10 kDal 5. molecular weight between 3 kDal and 5 kDal 6. molecular weight less than 3 kDal 7. chromatography M1 chromatography M2 9. chromatography M3
3.7 Inhibitory activity of T. molitor ACE inhibitory peptides on Staphylococcus aureus
As shown in Table 4 and Figure 9, only few of the ACE inhibitory peptides that underwent enzymolysis and purification exerted inhibitory effects on S. aureus. Only the enzymatic hydrolysis solution and the ACE inhibitory peptides > 30 kDa in molecular weight displayed antimicrobial effects. This result may be attributed to the fact that only the macromolecular polypeptides contain polypeptide fragments with inhibitory effects on S. Aureus.
Fig. 9 The antibacterial effect against Staphylococcus aureus of ACE inhibitory peptide from tenebrio molitor
Table 4: The antibacterial against Staphylococcus aureus of Tenebrio Molitor ACE inhibitory peptide
|
Numbers |
Types |
Diameter of antibacterial circle(mm) |
|
|
1 |
enzymatic hydrolysis solution |
6.65±0.25 |
|
|
2 |
M>30 kDal |
7.33±0.28 |
|
|
3 |
10 kDal<M<30 kDal |
none |
|
|
4 |
5 kDal<M<10 kDal |
none |
|
|
5 |
3 kDal<M<5 kDal |
none |
|
|
6 |
<3 kDal |
none |
|
|
7 |
M1 |
none |
|
|
8 |
M2 |
none |
|
|
9 |
M3 |
none |
|
Hydrolysis of T. molitor proteins by papain increased the ACE inhibition rate added up to 72.11% and yielded an IC50 of 0.6052 mg/mL on the basis of ultrafiltration and Sephadex G15 separation. The inhibition rate of the proteins after separation and purification significantly increased (p < 0.05). The polypeptides that displayed ACE inhibitory effect possessed a relatively small molecular weight (378 Da), contained a high amino acid content, and comprised three amino acid residues whose sequence may be Gly-Arg-Phe. Alternaria was selected as the indicator bacteria, and E. coli and S. aureus epiphyte were selected as the indicator epiphyte. The enzymatic hydrolysis solution and the liquid component were subjected to the inhibitory test after isolation and purification. The ACE inhibitory peptides, particularly the polypeptide fragments with a large molecular weight, elicited antibacterial effects. The enzymatic hydrolysis solution and the component > 30 kDa in molecular weight showed certain inhibitory effects on the three indicator epiphytes. The strongest bacteriostasis to Alternaria alternata was depicted by the 10–30 kDa enzyme solutions, with an inhibition zone of up to 5.15 mm. The strongest bacteriostasis to E. coli and S. aureus was exhibited by the 30 kDa enzyme solutions, with inhibition zones of 7.37 and 7.33 mm, respectively. The T. molitor ACE inhibitory peptides may be further separated and purified by a liquid equipment to provide a powerful evidence for the study of Tenebrio ACE inhibitory peptide QSAR and new synthetic methods of peptide segments. T. molitor as a raw material for the preparation of bioactive peptides can be used to process natural antibacterial agents.
Ren H. Preparation of rapeseed protein ACE inhibitory peptide and purification researching [D]. Hunan: Hunan Agricultural University, 2011
Maria MY.&Justo P.&Julio GC. Production of ace inhibitory peptides by digestion of chickpea legumin with Alcalase[J]. Food Chemistry. 2003, 81:363-369. 00431-4
View ArticleWu JP.&Ding XL. The development of soybean antihypertensive peptides (1) - production and screening of highly active ACEI peptides [J]. 1998, 23 (2): 49 - 51.
Hirofumi M.&Toshiaki K. Isolation and characterization of angiotensin I-converting enzyme inhibitory peptides from wheat gliadin hydrolysate[J]. Nahrung/Food, 2003, 47(5):354-358. PMid:14609094
View Article PubMed/NCBILi GH.&Shi YH.&Le GW. Alcalase Hydrolysates of Peanut ProteinIsolates Inhibit Angiotensin I-converting Enzyme Activity[J]. Food Science. 2005, 26(6):55-61.
Min SM.&In YB.&Hyeon GL. Purification and identificationof angiotensin I-converting enzyme inhibitory peptide from buckwheat (Fagopyrumesculentum Moench)[J]. Food Chemistry. 2006, 96:36-42.
View ArticleLiu P.&Li BC.&Yang YJ. Enzymatic hydrolysis of corn protein for preparation antihypertensive peptide [J]. Science and Technology of Food Industry. 2006, 27 (5): 117 - 122.
Chi YJ.&Zhang RD.&Ruan CQ. Preparation of ACE inhibitory peptides by enzymatic hydrolysis of egg white protein [J]. Food Science. 2010, 31 (14): 1-3.
Li Y.&Wang Y. Enzymatic hydrolysis of defatted silkworm chrysalis protein foe preparation ACE inhibitory peptide [J]. Food science, 2012 (17): 151-157
Cai LL.&Xu X. Optimization small yellow croaker ACE inhibitory peptide enzyme condition through response surface method [J]. Food Science. 2011, 32 (23): 167-171.
Ferreira I.M.P.L.V.O&Pinho O&Mota M.V. Preparation of ingredients containing an ACE-inhibitory peptide by tryptic hydrolysis of whey protein concentrates[J]. International Dairy Journal, 2007, (17): 481-487.
View ArticleJose'Angel GR.&Mercedes R.&Isidra R. Angiotensin convertingenzyme inhibitory activity of peptides isolated from Manchego cheese. Stabilityunder simulated gastrointestinal digestion[J]. International Dairy Journal. 2004, (14):1075-1080.
Zhou HX.&Ma L.&Zhang YH. Research status and application of antihypertensive peptides in food [J]. Food and Fermentation Technology. 2012,48 (1): 15 - 11.
Zhang LS.&Zhang JX. The separation and purification researching of Tenebrio molitor antioxidant peptides [J]. Food Science. 2009, 30 (22): 180-183.
Zhao Y.&Li B.&Liu Z. Antihypertensive effect and purification of an ACE inhibitory peptide from sea cucumber gelatin hydrolysate [J]. Process Biochemistry, 2007, 42(12): 1586-1591.
View ArticleKohmura M.&Nio N.&Ariyosh Y. Inhibition of angiotensin-converting enzyme by synthetic peptide fragments of human-casein [J]. Agricultural and Biological Chemistry. 1990, 54: 835-836.
View ArticleHuang JY.&Zhu YJ.&Shen JY. Research progress of antihypertensive peptides [J]. Food and FermentationIndustry. 2006, 32 (6): 81-86.
Gebre, A. K.; Altaye, B. M.; Atey, T. M.; Tuem, K. B.; Berhe, D. F. Targeting renin-angiotensin system against alzheimer's disease. Front. Pharmacol. 2018, 9,440. PMid:29760662
View Article PubMed/NCBIDaskaya-Dikmen, C.; Yucetepe, A.; Karbancioglu-Guler, F.; Daskaya, H.; Ozcelik, B. Angiotensin-IConverting enzyme (ACE)-inhibitory peptides from plants. Nutrients. 2017, 9, 316. PMid:28333109
View Article PubMed/NCBIBleakley, S.; Hayes, M.; O' Shea, N.; Gallagher, E.; Lafarga, T. Predicted release and analysis of novel ACE-I, renin, and DPP-IV inhibitory peptides from common oat (Avena sativa) protein hydrolysates using in silicoanalysis. Foods. 2017, 6, 108. PMid:29207547
View Article PubMed/NCBICushmanh DW.&Cheung HS. Spectrophotometricassay and properties of the angiotensin-converting enzyme of rabbit lung[J]. Bio-chemical Pharmacology. 1971, 20(7): 1637-1648. 90292-9
View ArticleChen J., Liu Y., Wang G., Sun S., Liu R., Hong B., Gao R., Bai K. Processing Optimization and Characterization of Angiotensin-I-Converting Enzyme Inhibitory Peptides from Lizardfish (Synodus macrops) Scale Gelatin. Mar. Drugs. 2018, 16, 228. PMid:29973522
View Article PubMed/NCBIZhang C., Sun L.C., Yan L.J., Lin Y.C., Liu G.M., Cao M.J. Production, optimisation and characterisation of angiotensin converting enzyme inhibitory peptides from sea cucumber (Stichopus japonicus) gonad. Food Funct. 2018,9:594-603. PMid:29271447
View Article PubMed/NCBIWang.C., Tu.M.L., Wu.D., Chen.H, Chen.C., Wang.Z.Y., Jiang.L.Z. Identification of an ACE-Inhibitory Peptide from Walnut Protein and Its Evaluation of the Inhibitory Mechanism.Mol Sci. 2018,4:1156.
Shi.A.M., Liu, H.Z.,Liu, L.,Hu, H., Wang, Q., Adhikari, B. Isolation, Purification and Molecular Mechanism of a Peanut Protein-Derived ACE-Inhibitory Peptide. PLOS ONE 2014, 9, e111188. PMid:25347076
View Article PubMed/NCBIRen H. Preparation of rapeseed protein ACE inhibitory peptide and purification researching. Hunan: Hunan Agricultural University, 2011.
Manoharan.S., Shuib.A.S., Abdullah.N. Structural Characteristics and Antihypertensive Effects of Angiotensin-I-Converting Enzyme Inhibitory Peptides in The Renin-Angiotensin and Kallikrein Kinin Systems. Afr J Tradit Complement Altern Med. 2017; 14(2): 383-406. PMid:28573254
View Article PubMed/NCBIDeng Z.Z., Liu Y.J., Wang J., Wu S.H., Geng L.H., Sui Z.H., Zhang Q.B. Antihypertensive Effects of Two Novel Angiotensin I-Converting Enzyme (ACE) Inhibitory Peptides from Gracilariopsis lemaneiformis (Rhodophyta) in Spontaneously Hypertensive Rats (SHRs) Mar. Drugs. 2018;16:299. PMid:30150552
View Article PubMed/NCBIWang X., Yu H., Xing R., Li P. Characterization, Preparation, and Purification of Marine Bioactive Peptides. BioMed Research International. 2017:16.
View ArticleGarcía-Moreno P.J., Espejo-Carpio F.J., Guadix A., Guadix E.M. Production and identification of angiotensin I-converting enzyme (ACE) inhibitory peptides from Mediterranean fish discards. J. Funct. Foods. 2015;18:95-105.
View ArticleSoriano-Santos J, Escalona-Buendía HB. Angiotensin I-converting enzyme inhibitory and antioxidant activities and surfactant properties of protein hydrolysates as obtained of Amaranthus hypochondriacus L. grain. J Food Sci Technol. 2015;52:2073-2082. PMid:25829587
View Article PubMed/NCBIWang WL. The researching of Tenebrio molitor amino acid oral liquid[D]. Shandong: Shandong Agricultural University, 2006.
Zhang LS., Zhang JX. The separation and purification researching of Tenebrio molitor antioxidant peptides [J]. Food Science. 2009, 30 (22): 180-183.
Li C., Zhu J., Wang Y., Chen Y., Song L., Zheng W., Li J. Antibacterial activity of Al-hemocidin 2, a novel N-terminal peptide of hemoglobin purified from arca inflate. Mar. Drugs. 2017,15:205. PMid:28661457
View Article PubMed/NCBIWang.Z.L. , Wang X.M., Wang.J.H. Recent Advances in Antibacterial and Antiendotoxic Peptides or Proteins from Marine Resources.Mar Drugs.2018, 16(2): 57. PMid:29439417
View Article PubMed/NCBIIbrahim HR, Ahmed AS, Miyata T. Novel angiotensin-converting enzyme inhibitory peptides from caseins and whey proteins of goat milk. J Adv Res. 2017;8(1):63-71. PMid:28053783
View Article PubMed/NCBI